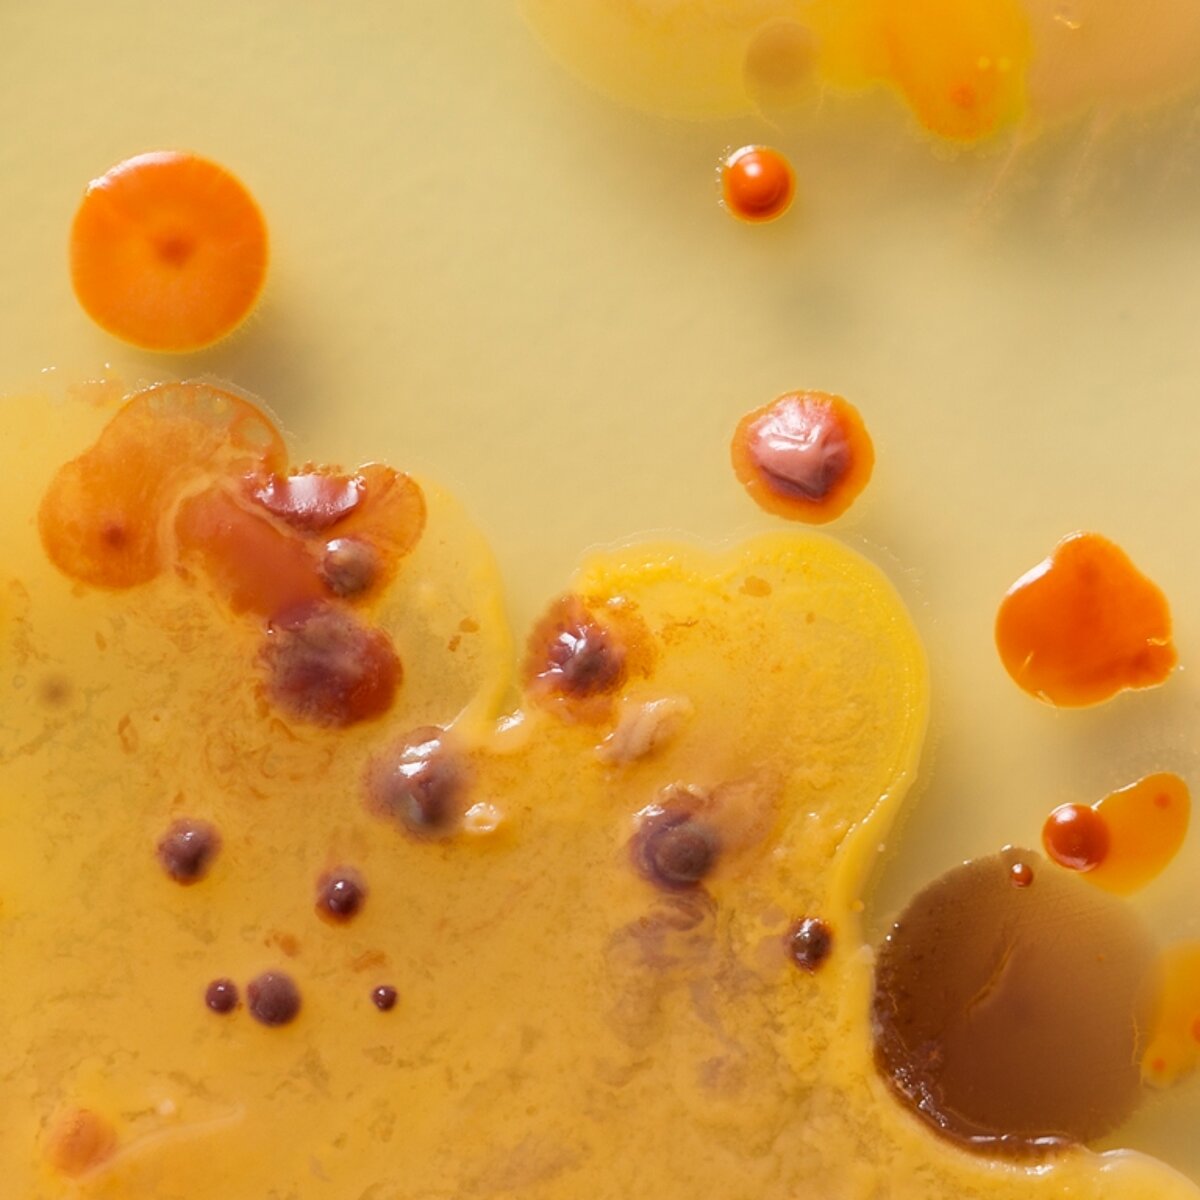

Microbiology and biotechnology facilities

Microbiology and biotechnology facilities
o Standard microbiology laboratories, equipped for L2 and S1 work including autoclaves, laminar flow microbiological workbench
o 6-fold parallel fermentation device for process development (Multifors, Infors)
o 300L- Pilot scale fermentation (Techfors, Infors) and respective cleaning in place (CIP)
o 10 L fermenter (Biostat, Braun)
o Flow through process centrifuge (Z61, CEPA)
o Cross flow filtration for 50L batches
o Spray dryer (B-290, Büchi)
o Diversity of shakers and incubators
o Incubation rooms
o Homogenizers (French Press, cell mill, Pulverisette)
o - 80 °C and -100 °C freezers, Liquid nitrogen storage
o Microscope (Axioscope 40, Zeiss)
o Molecular lab including thermocyclers (T200, Biometra), electrophoresis equipment and imager (Intas)